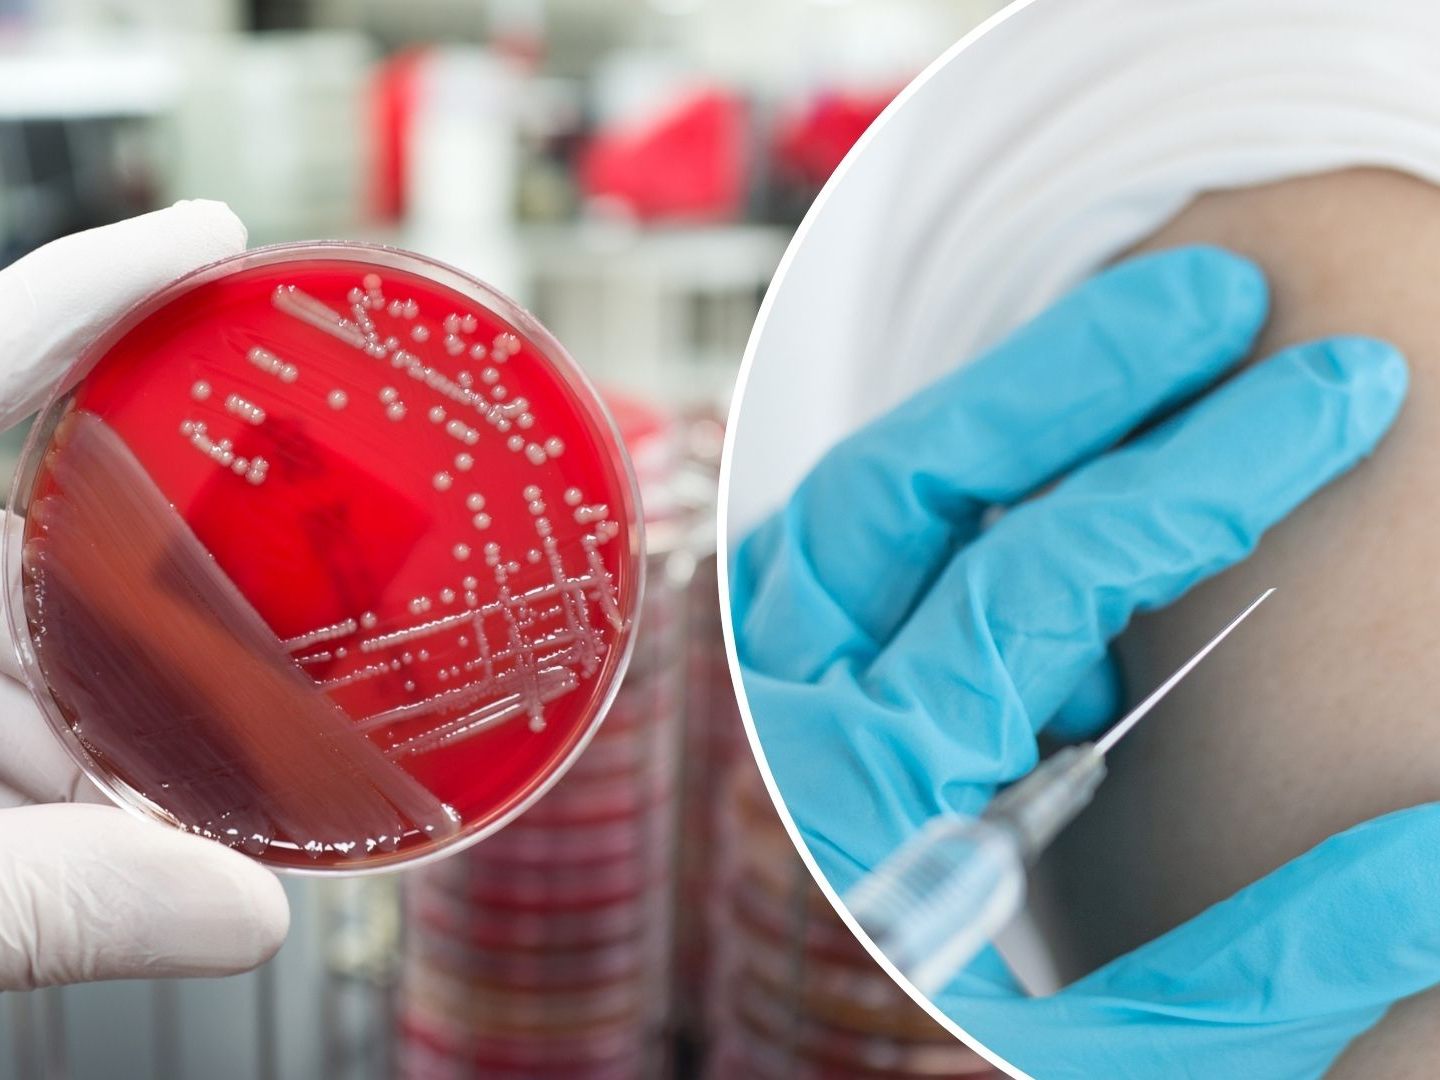
Die WHO veröffentlichte erstmals eine Liste mit den gefährlichsten Viren und Bakterien. (Symbolbild)

Die gefährlichsten Erreger ohne Impfstoff – WHO schlägt Alarm
Ziel ist es, die Entwicklung neuer Impfstoffe zu beschleunigen.
WHO priorisiert gefährlichste Krankheitserreger
Die WHO hat erstmals eine globale Rangliste von endemischen Krankheitserregern erstellt, die aufgrund ihrer Gefährlichkeit und hohen Verbreitung priorisiert werden sollen. Insgesamt listet die Organisation mehrere Viren, Bakterien und andere Pathogene, für die es weltweit noch keine effektiven Impfstoffe gibt.
Die Liste wurde erstellt, um Forschung und Entwicklung in der Impfstoffproduktion gezielt zu lenken. Besonders häufig betroffen sind Menschen in den am stärksten gefährdeten Regionen, die keinen Zugang zu Schutzimpfungen haben.
Kriterien der WHO: Gefährlichkeit und potenzielle Wirkung
273 internationale Experten der WHO analysierten Faktoren wie:
- Todesfälle insgesamt und speziell unter Kindern,
- Langzeitfolgen für die Gesundheit,
- Resistenzen gegen Antibiotika,
- Kosten für Gesundheitssysteme und Betroffene,
- wirtschaftliche und gesellschaftliche Auswirkungen.
Diese Daten wurden regional aufbereitet und mündeten in einer globalen Liste. Sie soll Forschungseinrichtungen, Geldgeber und Regierungen gleichermaßen als Orientierung dienen.
Die gefährlichsten Pathogene der Welt
Die Liste enthält Erreger, die jedes Jahr Millionen Menschen betreffen und hohe Sterblichkeitsraten verursachen. Einige Beispiele:
Pathogene ohne Impfstoffe:
- HIV
- Hepatitis C
- Streptokokken der Gruppe A
- Multiresistentes Bakterium Klebsiella pneumoniae
Pathogene mit unzureichenden Impfstoffen:
- Malaria
- Influenza
- Streptokokken der Gruppe A
- Multiresistentes Bakterium Klebsiella pneumoniae
Krankheiten mit entwickelten, aber nicht zugelassenen Impfstoffen:
- Dengue-Virus
- Streptokokken der Gruppe B
- Tuberkulose
- RS-Virus
Bedeutung der Liste für Impfprogramme
Mit der Priorisierung dieser Krankheitserreger sollen systematische und faire Entscheidungsgrundlagen für Impfstoffentwicklungen geschaffen werden. Dies dient auch der Europäischen Impfagenda 2030, die allen Menschen in Europa den Zugang zu essenziellen Impfstoffen ermöglichen will.
"Allzu oft wurden Entscheidungen über Impfstoffe allein von finanziellen Interessen beeinflusst, nicht aber von der Zahl der Menschenleben, die gerettet werden könnten", sagte Kate O’Brien von der WHO. Ziel sei es, Gesundheitssysteme zu entlasten und Infektionskrankheiten langfristig einzudämmen.
(VOL.AT)
Du hast einen Hinweis für uns? Oder einen Insider-Tipp, was bei dir in der Gegend gerade passiert? Dann melde dich bei uns, damit wir darüber berichten können.
Wir gehen allen Hinweisen nach, die wir erhalten. Und damit wir schon einen Vorgeschmack und einen guten Überblick bekommen, freuen wir uns über Fotos, Videos oder Texte. Einfach das Formular unten ausfüllen und schon landet dein Tipp bei uns in der Redaktion.
Alternativ kannst du uns direkt über WhatsApp kontaktieren: Zum WhatsApp Chat
Herzlichen Dank für deine Zusendung.


